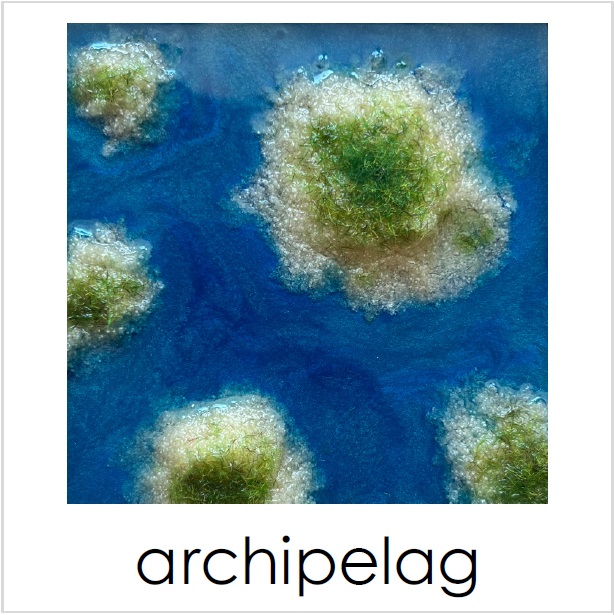

PANELE TEMATYCZNE
Panele tematyczne – edukacja sensoryczna przez zabawę i eksplorację
W kategorii panele tematyczne znajdziesz unikalne, ręcznie tworzone pomoce sensoryczne, które rozwijają dziecięcą wyobraźnię, motorykę oraz integrację sensoryczną. Każdy panel to mała przygoda w formie edukacyjnej makiety, idealna do zabaw indywidualnych i grupowych w domu, przedszkolu czy sali terapeutycznej.
Co wyróżnia nasze panele?
🎨 Tematyczne makiety sensoryczne – np. farma, budowa, las, wulkan, ocean, kosmos
🌾 Różnorodne faktury i naturalne materiały – stymulacja dotykowa i rozwój zmysłów
✋ Rozwijanie motoryki małej – ćwiczenia chwytu, manipulacji i koordynacji wzrokowo-ruchowej
📚 Wprowadzenie do świata przyrody i środowiska – edukacja poprzez doświadczenie
Zalety paneli tematycznych:
✔️ Wspierają rozwój poznawczy i sensoryczny
✔️ Zachęcają do kreatywnej zabawy i samodzielnego odkrywania
✔️ Pomagają w pracy z dziećmi ze spektrum autyzmu, zaburzeniami SI i innymi trudnościami rozwojowymi
✔️ Ułatwiają naukę poprzez łączenie bodźców wzrokowych, dotykowych i słuchowych
Idealne dla:
👉 Przedszkoli i szkół
👉 Terapeutów integracji sensorycznej
👉 Gabinetów pedagogicznych i logopedycznych
👉 Rodziców dzieci w wieku przedszkolnym i wczesnoszkolnym
Panele tematyczne ArtSenso to narzędzie, które łączy naukę z radością odkrywania. Każdy zestaw został zaprojektowany tak, by angażować dziecko, stymulować zmysły i rozwijać ciekawość świata. Sprawdź dostępne wzory i dobierz idealny panel dla swojej przestrzeni edukacyjnej!
Wyświetlanie 1–50 z 51 wynikówPosortowane według najnowszych
-
Mroźna Kraina – Arktyka – kwadrat 23×23 cm OUTLET
Pierwotna cena wynosiła: 119,00 zł.99,00 złAktualna cena wynosi: 99,00 zł. Dodaj do koszyka CZYSZCZENIE MAGAZYNU! -
GÓRY – makieta sensoryczna Montessori do odgrywania ról
Zakres cen: od 169,00 zł do 359,00 zł Wybierz opcje Ten produkt ma wiele wariantów. Opcje można wybrać na stronie produktu FLISAT / TROFAST -
DŻUNGLA – makieta sensoryczna Montessori do odgrywania ról
Zakres cen: od 159,00 zł do 349,00 zł Wybierz opcje Ten produkt ma wiele wariantów. Opcje można wybrać na stronie produktu FLISAT / TROFAST -
Sensoryczne Krainy Zwierząt – zestaw 6 paneli sensorycznych Montessori
840,00 zł Dodaj do koszyka MAKIETY SENSORYCZNE -
Panel MAGICZNA KRAINA z tęczą – makieta sensoryczna do odgrywania ról
Zakres cen: od 159,00 zł do 349,00 zł Wybierz opcje Ten produkt ma wiele wariantów. Opcje można wybrać na stronie produktu FLISAT / TROFAST -
OCEAN z RAFĄ KORALOWĄ – makieta sensoryczna Montessori do odgrywania ról
Zakres cen: od 159,00 zł do 349,00 zł Wybierz opcje Ten produkt ma wiele wariantów. Opcje można wybrać na stronie produktu FLISAT / TROFAST -
LAS – Leśna Polana – makieta sensoryczna Montessori do odgrywania ról
Zakres cen: od 149,00 zł do 339,00 zł Wybierz opcje Ten produkt ma wiele wariantów. Opcje można wybrać na stronie produktu MAKIETY SENSORYCZNE -
OCEAN, PLAŻA – „Morskie Opowieści” – makieta sensoryczna Montessori do odgrywania ról
Zakres cen: od 149,00 zł do 329,00 zł Wybierz opcje Ten produkt ma wiele wariantów. Opcje można wybrać na stronie produktu MAKIETY SENSORYCZNE -
WULKAN – Park Jurajski – makieta sensoryczna Montessori do odgrywania ról
Zakres cen: od 159,00 zł do 339,00 zł Wybierz opcje Ten produkt ma wiele wariantów. Opcje można wybrać na stronie produktu MAKIETY SENSORYCZNE -
ARKTYKA – „Mroźna Kraina” – makieta sensoryczna Montessori do odgrywania ról
Zakres cen: od 149,00 zł do 329,00 zł Wybierz opcje Ten produkt ma wiele wariantów. Opcje można wybrać na stronie produktu MAKIETY SENSORYCZNE -
WIEŚ – Wiejskie życie – makieta sensoryczna Montessori do odgrywania ról
Zakres cen: od 159,00 zł do 339,00 zł Wybierz opcje Ten produkt ma wiele wariantów. Opcje można wybrać na stronie produktu MAKIETY SENSORYCZNE -
SAFARI – „Afryka Dzika” – makieta sensoryczna Montessori do odgrywania ról
Zakres cen: od 149,00 zł do 329,00 zł Wybierz opcje Ten produkt ma wiele wariantów. Opcje można wybrać na stronie produktu MAKIETY SENSORYCZNE -
PLAC BUDOWY – makieta sensoryczna Montessori do odgrywania ról
Zakres cen: od 159,00 zł do 339,00 zł Wybierz opcje Ten produkt ma wiele wariantów. Opcje można wybrać na stronie produktu MAKIETY SENSORYCZNE -
Ziemia – panel tematyczny sensoryczny, makieta Montessori
Pierwotna cena wynosiła: 145,00 zł.119,00 złAktualna cena wynosi: 119,00 zł. Dodaj do koszyka DOSTĘPNE OD RĘKI -
MIODZIO – panel multisensoryczny do ścieżki sensorycznej nowa wersja – dary ula
159,00 zł Dodaj do koszyka MULTISENSORYKA -
Sensoryczny Układ Słoneczny Montessori z tacą KOSMOS Planety sensoryczne – bez żywicy
299,00 zł Dodaj do koszyka GEOGRAFIA I ASTRONOMIA -
Panel sensoryczny Ziemia i jej wnętrze – budowa wnętrza Ziemi XXL
Zakres cen: od 399,00 zł do 479,00 zł Wybierz opcje Ten produkt ma wiele wariantów. Opcje można wybrać na stronie produktu GEOGRAFIA I ASTRONOMIA -
Panel tematyczny LEŚNA POLANA – nakładka na stolik Ikea FLISAT
229,00 zł Dodaj do koszyka FLISAT / TROFAST -
Panel tematyczny PLAC BUDOWY – nakładka na stolik FLISAT
229,00 zł Dodaj do koszyka FLISAT / TROFAST -
Panel sensoryczny Ziemia i jej wnętrze – budowa wnętrza Ziemi
Zakres cen: od 199,00 zł do 279,00 zł Wybierz opcje Ten produkt ma wiele wariantów. Opcje można wybrać na stronie produktu GEOGRAFIA I ASTRONOMIA -
Panel tematyczny Skarby Jesieni Standard
Pierwotna cena wynosiła: 139,00 zł.99,00 złAktualna cena wynosi: 99,00 zł. Dodaj do koszyka CZYSZCZENIE MAGAZYNU! -
Panel tematyczny MORSKIE OPOWIEŚCI – nakładka na stolik Ikea FLISAT / TROFAST
Pierwotna cena wynosiła: 229,00 zł.199,00 złAktualna cena wynosi: 199,00 zł. Dodaj do koszyka FLISAT / TROFAST -
Panel tematyczny PARK JURAJSKI z wulkanem – nakładka na stolik Ikea FLISAT
229,00 zł Dodaj do koszyka FLISAT / TROFAST -
Sensoryczny Układ Słoneczny Montessori z tacą KOSMOS Planety sensoryczne
399,00 zł Dodaj do koszyka GEOGRAFIA I ASTRONOMIA -
Panel tematyczny AFRYKA DZIKA – nakładka Ikea FLISAT / TROFAST
199,00 zł Dodaj do koszyka FLISAT / TROFAST -
Panel tematyczny MROŹNA KRAINA FLISAT / TROFAST IKEA nakładka
199,00 zł Dodaj do koszyka FLISAT / TROFAST -
Formy ukształtowania lądu i wody – karty edukacyjne Montessori
6,00 zł Wybierz opcje Ten produkt ma wiele wariantów. Opcje można wybrać na stronie produktu GEOGRAFIA I ASTRONOMIA -
Fazy Księżyca z tabliczkami – panel sensoryczny sorter Montessori
165,00 zł Wybierz opcje Ten produkt ma wiele wariantów. Opcje można wybrać na stronie produktu GEOGRAFIA I ASTRONOMIA -
Panel tematyczny MROŹNA KRAINA XXL
Pierwotna cena wynosiła: 249,00 zł.229,00 złAktualna cena wynosi: 229,00 zł. Dodaj do koszyka Montessori -
FORMY UKSZTAŁTOWANIA LĄDU I WODY Montessori – tabliczki
219,00 zł Dodaj do koszyka GEOGRAFIA I ASTRONOMIA -
FORMY UKSZTAŁTOWANIA LĄDU I WODY Montessori z tacą
429,00 zł Dodaj do koszyka GEOGRAFIA I ASTRONOMIA -
Panel tematyczny AFRYKA DZIKA XXL
Pierwotna cena wynosiła: 249,00 zł.229,00 złAktualna cena wynosi: 229,00 zł. Dodaj do koszyka Montessori